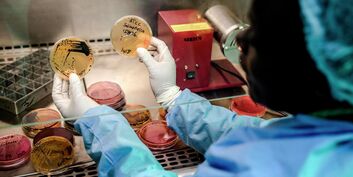

Скоро
Евразийскому центру имени Льва Гумилева 15 лет
Наблюдательная миссия Общественной палаты РФ в Танзании: выборы, встречи, массовые беспорядки
IV Медиафорум стран СНГ "Развитие медиа в меняющемся мире"
Инженеры будущего. Разработки ученых, которые меняют мир уже сегодня
Фестиваль "Крымское вдохновение", объединяющий народы России
Цифровые проекты ЕАЭС
Первый Всероссийский конгресс наблюдателей
Торжественная церемония награждения лауреатов медали РАО "Молодым ученым за успехи в науке"
Творческая встреча с народным артистом России, режиссером Андреем Житинкиным
Заседание Координационного совета РАН и РАО "Здоровье и образование детей, подростков и молодежи"
XIV Московский международный форум "Корпоративное волонтерство: бизнес и общество"
IV Ежегодная научно-практическая конференция "Сложный пациент в акушерстве и гинекологии"
Всемирная неделя повышения осведомленности о проблеме устойчивости к противомикробным препаратам
Формула эволюции. Научные исследования для технологического развития России
Календарь мероприятий
Российско-китайское взаимодействие: актуальная повестка
- Москва
- Стеклянный зал
Счастливая семья: как сохранить традиционные ценности в Казахстане
- За рубежом
- Астана
Прямая трансляция
Итоги Всероссийского фестиваля популяризации науки "Вектор победы"
- Москва
- Стеклянный зал
Прямая трансляция
Наблюдательная миссия Общественной палаты РФ в Танзании: выборы, встречи, массовые беспорядки
- Москва
- Малый зал
Прямая трансляция
Евразийскому центру имени Льва Гумилева 15 лет
- Москва
- За рубежом
- Тбилиси
- Бизнес зал
Развитие сотрудничества профсоюзов стран СНГ
- За рубежом
- Ташкент
Прошедшие мероприятия
Развитие сотрудничества профсоюзов стран СНГ
Российско-китайское взаимодействие: актуальная повестка
Счастливая семья: как сохранить традиционные ценности в Казахстане
О чем кричит "Буревестник"? Новые российские ядерные технологии меняют мировую повестку
Пресс-конференция по итогам участия российской делегации в саммите АТЭС
Межнациональное согласие как основа единства России
10 ноября — День сотрудника органов внутренних дел
Пресс-конференция председателя Комитета Госдумы РФ по защите семьи, вопросам отцовства, материнства и детства Нины Останиной
XII Общецерковный съезд по социальному служению
Подпишитесь на нашу рассылку
Подписаться